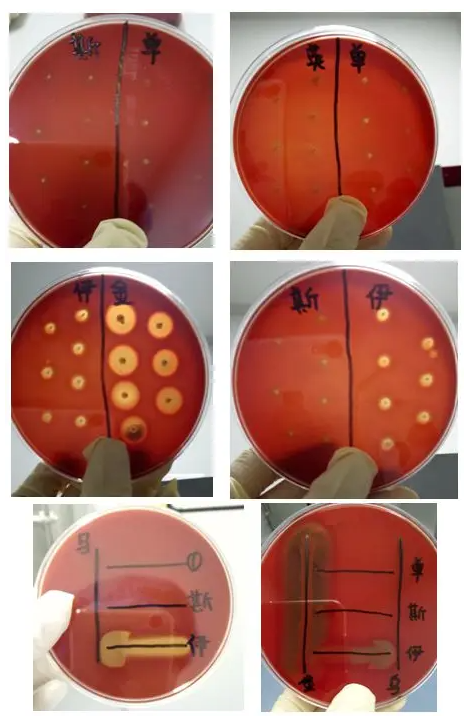

1、确定参数:实验室质控部门一般会告知能力验证样品基本信息。我们实验是参数是单核增生李斯特。
2、确定检测方法:GB 4789.30定性检验。
3、确认实验方案:把所涉及的试剂进行排查,查询是否缺某种试剂;整个实验流程按思路整理下来,便于实验操作时记录每天实验完成情况及结果。
4、配置所需培养基:无菌水、FB1、FB2、PALCAM、单增显色板、TSA-YE等。
二、实验操作
1、阅读说明书,水化冻干粉(如下图)

注意事项:多多少少做了好几次能力验证,这里水化时建议提前准备无菌三角瓶或者无菌袋,分四次水化安培瓶,每次5mL。最后水化共计40mL混匀备用。
开取西林瓶时,注意盲样状态是否完好,若是洒落,记得拍照留下证据。
2、实验步骤
2.1吸取25ml水化的样品加入225mL的FB1培养基中,30℃培养24h。
注意事项:在这里,我们可以先分别分离菌落在PALCAM、单增显色板上, 36℃培养24-48h.看是否有杂菌或者是否无菌生长,给后面实验提供信息(如下图左),同时需要带上单核增生李斯特标准菌株ATCC19115(如下图右),以及单增系列的辅助标准菌株(见后面)。
这里我们的实验结果:一个平板无菌生长;一个平板菌落典型蓝紫色,类似标准菌株。
2.2 从FB1培养基吸取0.1mL加入LB2培养基中,30℃培养24h。
2.3 从FB2培养基中挑取一环分离在PALCAM、单增显色板上,培养36℃24-48h,对比之前未选择性增菌的PALCAM、单增显色板。
注意事项:一般定性检测会加干扰菌,经过FB1 FB2的选择性增菌,既增加了单增的目标菌,又抑制了杂菌,所以这一步很重要。经过选择性增菌后实验结果:一个平板淡黄色、圆形、光滑、湿润;一个平板菌落典型蓝紫色,类似标准菌株.
2.4 初筛
自选择性琼脂平板上分别挑取3个~5个典型或可疑菌落,分别接种木糖、鼠李糖 发酵管,于36 ℃±1 ℃培养24h±2h,同时在 TSA-YE平板上划线,于36℃±1℃培养18h~24h,然后选择木糖阴性、鼠李糖阳性的纯培养物继续进行鉴定。
挑取一单独菌落分别接种木糖与鼠李糖,如下图:
注意事项:以上图片为单增标准菌株以及各种辅助标准菌株的木糖、鼠李糖实验结果。然后选择木 糖阴性、鼠李糖阳性的纯培养物继续进行鉴定。
2.5 鉴定
2.5.1 用上述的平板进行生化鉴定实验,按照试剂条说明书进行和标准菌株对比如下:

2.5.2 染色镜检:革兰氏阳性短杆菌,如下图:
注意事项:右图是左图蓝色区域的放大。
2.5.3 动力试验挑取纯培养的单个可疑菌落穿刺半固体SIM 动力培养基,于25 ℃~30 ℃培养 48h,李斯特氏菌有动力,在半固体或 SIM 培养基上方呈伞状生长,如伞状生长不明显,可继续培养 5d,再观察结果。
2.5.4 生化鉴定:挑取纯培养的单个可疑菌落,进行过氧化氢酶试验,过氧化氢酶阳性反应的菌落继续 进行糖发酵试验和 MR-VP试验。过氧化氢酶试验:阳性,如下图:
注意事项:A是空白,B、C是阳性反应。
2.5.5 溶血试验:
单增李斯特氏菌在刺种点周围产生狭小的透明溶血环;斯氏李斯特氏菌在刺种点周围产生狭小的透明溶血环;英诺克李斯特氏菌无溶血环;伊氏李斯特氏菌产生大的透明溶血环。
如下图:
注意事项:单核增生李斯特氏菌在靠近金黄色葡萄球菌的接种端溶血增强;斯氏李斯特氏菌的溶血也增强;伊氏李斯特氏菌在靠近马红球菌的接种端溶血增强。
2.6 结果与报告 综合以上生化试验和溶血试验的结果,报告40mL样品中检出或未检出单核细胞增生李斯特氏菌。






